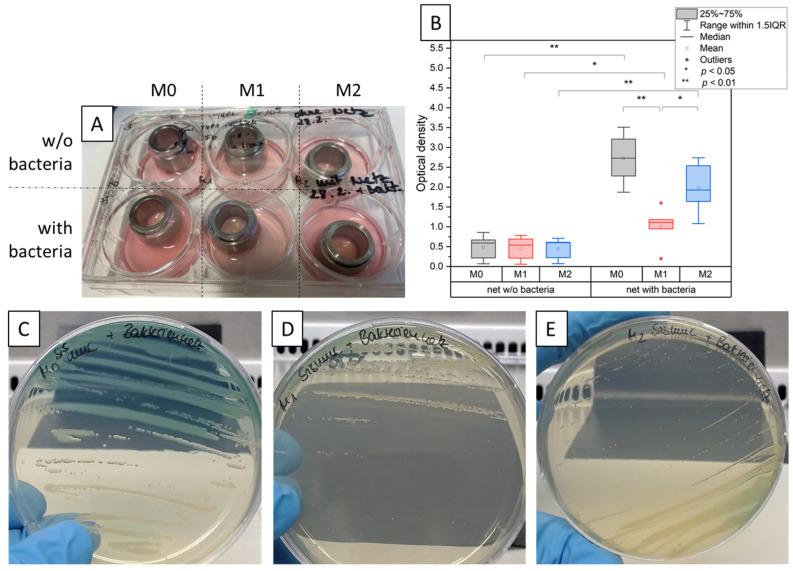
https://cdn.ncbi.nlm.nih.gov/pmc/blobs/dfd5/10885984/c5cbf0c8e1c9/bioengineering-11-00187-g003.jpg

建立一种具有人体免疫活性的3D组织模型以实现对生物膜与组织相互作用的长期研究。
Establishment of a Human Immunocompetent 3D Tissue Model to Enable the Long-Term Examination of Biofilm-Tissue Interactions.
作者信息
Murkar Rasika, von Heckel Charlotte, Walles Heike, Moch Theresia Barbara, Arens Christoph, Davaris Nikolaos, Weber André, Zuschratter Werner, Baumann Sönke, Reinhardt Jörg, Kopp Sascha
机构信息
Core Facility Tissue Engineering, Otto-von-Guericke University Magdeburg, Universitätsplatz 2, 39106 Magdeburg, Germany.
Department of Otorhinolaryngology, Head and Neck Surgery, University Clinic Giessen, 35392 Giessen, Germany.
出版信息
Bioengineering (Basel). 2024 Feb 15;11(2):187. doi: 10.3390/bioengineering11020187.
Different studies suggest an impact of biofilms on carcinogenic lesion formation in varying human tissues. However, the mechanisms of cancer formation are difficult to examine in vivo as well as in vitro. Cell culture approaches, in most cases, are unable to keep a bacterial steady state without any overgrowth. In our approach, we aimed to develop an immunocompetent 3D tissue model which can mitigate bacterial outgrowth. We established a three-dimensional (3D) co-culture of human primary fibroblasts with pre-differentiated THP-1-derived macrophages on an SIS-muc scaffold which was derived by decellularisation of a porcine intestine. After establishment, we exposed the tissue models to define the biofilms of the spec. and spec. cultivated on implant mesh material. After 3 days of incubation, the cell culture medium in models with M0 and M2 pre-differentiated macrophages presented a noticeable turbidity, while models with M1 macrophages presented no noticeable bacterial growth. These results were validated by optical density measurements and a streak test. Immunohistology and immunofluorescent staining of the tissue presented a positive impact of the M1 macrophages on the structural integrity of the tissue model. Furthermore, multiplex ELISA highlighted the increased release of inflammatory cytokines for all the three model types, suggesting the immunocompetence of the developed model. Overall, in this proof-of-principle study, we were able to mitigate bacterial overgrowth and prepared a first step for the development of more complex 3D tissue models to understand the impact of biofilms on carcinogenic lesion formation.
不同的研究表明生物膜对人体不同组织中致癌性病变的形成有影响。然而,癌症形成的机制在体内和体外都很难研究。在大多数情况下,细胞培养方法无法在没有任何过度生长的情况下维持细菌的稳定状态。在我们的方法中,我们旨在开发一种具有免疫活性的三维组织模型,该模型可以减轻细菌的过度生长。我们在通过猪小肠脱细胞获得的SIS-黏液支架上,将人原代成纤维细胞与预分化的THP-1来源的巨噬细胞建立了三维(3D)共培养。建立后,我们将组织模型暴露于在植入网片材料上培养的特定生物膜中。孵育3天后,含有M0和M2预分化巨噬细胞的模型中的细胞培养基出现明显浑浊,而含有M1巨噬细胞的模型则没有明显的细菌生长。这些结果通过光密度测量和划线试验得到验证。组织的免疫组织学和免疫荧光染色显示M1巨噬细胞对组织模型的结构完整性有积极影响。此外,多重ELISA突出了所有三种模型类型中炎性细胞因子释放的增加,表明所开发模型具有免疫活性。总体而言,在这项原理验证研究中,我们能够减轻细菌的过度生长,并为开发更复杂的三维组织模型以了解生物膜对致癌性病变形成的影响迈出了第一步。